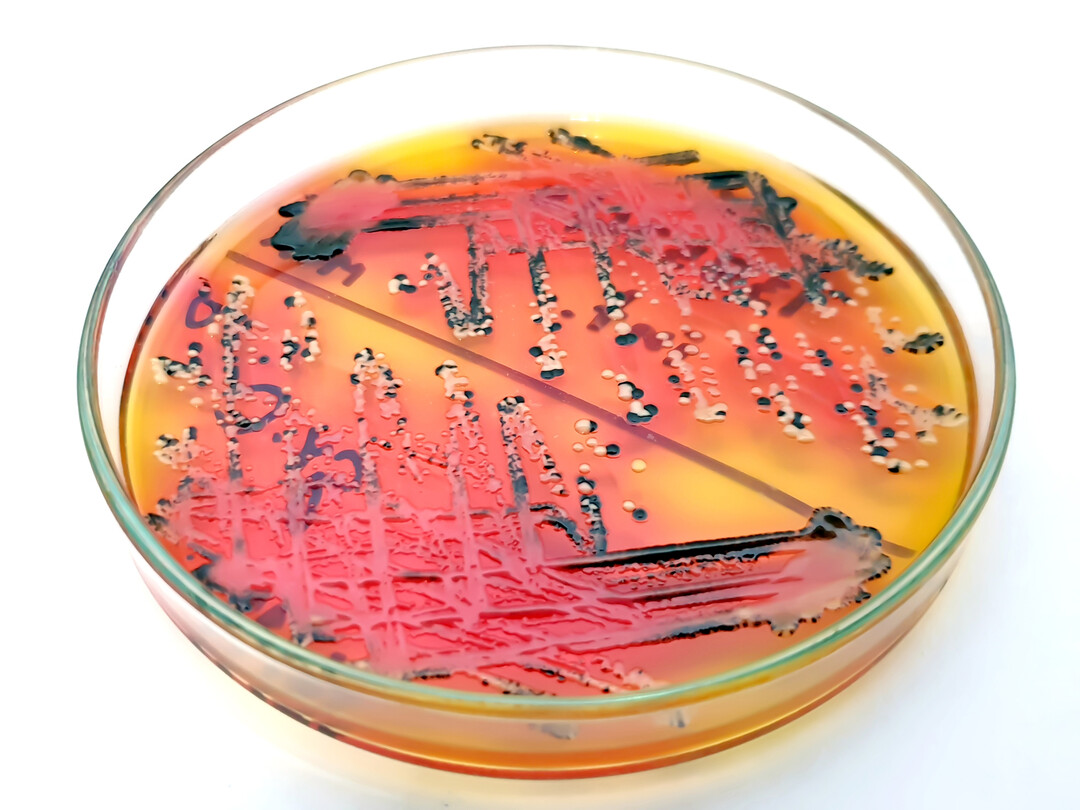
Mit einer gezielten Reinigung und Desinfektion lassen sich Viren, Bakterien, Pilze und Parasiten bek�mpfen. Wichtig ist dabei, die Zielobjekte, wie hier beispielsweise Salmonellen, zu kennen.

Biosicherheit
Desinfektion im Stall: Kenne die Keime
Für eine erfolgreiche Geflügelhaltung ist die richtige Stallreinigung und -desinfektion unabdingbar. Geert Hulpia, Experte für Mikrobiologie, erläutert in einem Vortrag auf dem Thüringer Geflügeltag 2025, wie typische Fehler vermieden werden können.
- Veröffentlicht am
Die Wahl des richtigen Desinfektionsmittels ist ein zentraler Faktor für eine erfolgreiche Stalldesinfektion. Ebenso entscheidend ist dessen richtige Anwendung, ansonsten droht die Wirkungslosigkeit der gesamten Maßnahme. Auf diese Punkte wies Geert Hulpia, Diplom-Chemiker und anerkannter Sachverständiger beim Bundesverband Deutscher Sachverständiger und Fachgutachter e. V., in seinem Vortrag auf dem Thüringischen Geflügeltag 2025 in Berlstedt hin. Er schilderte, welche Fehler sich bei dieser Arbeit einschleichen können und mit welchen Strategien sie sich vermeiden lassen. Eine erfolgreiche Stalldesinfektion beginnt laut Hulpia damit, dass der Landwirt zunächst prüft, welche Zielobjekte im Fokus stehen und wie empfindlich diese gegenüber...




